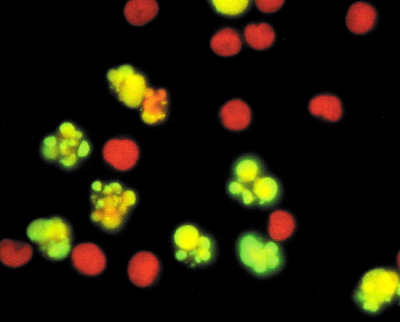
Cell Apoptosis cellular suicide

At its heart, cancer is the result of uncontrolled cell growth. Our bodies are composed of trillions of cells, all working together. In cancer, one of those cells stops paying attention to the normal signals that tell cells to grow, stop growing or even to die. Cancer cells still share many of the same needs and properties of normal cells but they become independent of the controls that make our body function smoothly. The process by which a normal cell changes into one that behaves so abnormally can take a long time and is often triggered by outside influences.1 The next few sections describe the differences between normal and cancer cells and outline the steps leading to the creation of a cancer cell from a normal cell.
Cancer is actually a general term that describes a large group of related diseases.1 Every case of cancer is unique, with its own set of genetic changes and traits. Some cancers grow quickly while others can take years to become dangerous to the patient. The many differences between cases of cancer, even of the same organ (i.e. different cases of breast cancer), is one of the main reasons that treating and curing cancer is so difficult.
Despite the differences between different types of cancer, all cancers DO share some common features,2 and these shared properties are the basis for many cancer treatments and research efforts. It is important to understand the basic, shared, features of cancer. This will allow an understanding of detection, diagnosis and treatment options.
There are several changes that must occur for a normal cell to become a cancer cell. Additional changes are needed for that single abnormal cell to form a group of cancer cells, called a tumor, and then for that tumor to grow and spread. An excellent review article detailing a model of cancer growth and spread was written by Douglas Hanahan and Robert Weinberg.2 The information covered in the following page is detailed in their paper. Click on the links below to learn more about the 'Hallmarks of Cancer'.
- Growth Without 'GO' Signals
- Failure to Respond to 'STOP' Signals
- Unlimited Number of Cell Divisions
- Avoidance of Cell Death
- Angiogenesis
- Tissue Invasion and Metastasis
- Physical Changes in Cancer Cells
- Genetic Instability and Cancer
- Summary
- Test yourself and see if you Know the Flow: Hallmarks of Cancer
More detailed information on these topics can be found in the Cancer Biology section of the site.
Hallmarks Of Cancer: Growth Without 'GO' Signals

Normal cells will not divide unless they receive outside signals that cause them to enter the cell cycle, the process that leads to cellular reproduction. The signals are detected outside the cell (on the cell surface) and sent into the cell. They come from three different sources; growth factors (what tells a cell to grow), cell-cell adhesion molecules (what connects one cell to another), and extracellular matrix components (a meshwork of proteins that exists outside of the cell). Normally these signals, along with other factors, help control the growth of cells, preventing them from dividing uncontrollably. Cancer cells develop the ability to grow in the absence of these external factors and no longer obey the normal regulations on cell division. They do this by, producing their own growth factors, alter their growth receptors to send more signals, and even influence surrounding cells to produce growth signals. At this point cancer cells begin to behave more like independent life forms - they grow and reproduce without regard for the organism as a whole.
Hallmarks Of Cancer: Failure To Respond To 'STOP' Signals
Normal cells obey signals from nearby cells. This prevents the cells from piling up or becoming too crowded.
The division of cells is normally prevented by signals from other cells nearby. Cells will stop dividing when they are in contact with their neighboring cells. Cell:cell contacts send signals into the dividing cells that cause them to stop dividing. An alternative mechanism to stop cell division is called differentiation. This is the process by which a cell matures to perform a specific job. An example of this is the maturation of stem cells in the bone marrow into white or red blood cells.
Cancer cells ignore 'Stop' signals and will pile up on each other.
Hallmarks Of Cancer: Unlimited Number Of Cell Divisions
While normal cells can only divide a limited number of times, cancer cells have the ability to divide endlessly without displaying the normal 'aging' seen in non-cancer cells. In many cancers this is due to the activity of an enzyme, telomerase, that maintains the ends of the chromosomes during cell division. The telomerase gene is normally turned off in most adult cells, but most cancer cells turn it back on and have active telomerase enzyme in them.
Cancer cells can reproduce an unlimited number of times. They are immortal.
The very first endlessly reproducing cancer cells were removed from a young woman named Henrietta Lacks. Henrietta died from cervical cancer in 1951, but the cells taken from her are still growing in laboratories around the world.3, 4
Hallmarks Of Cancer: Avoidance Of Cell Death
In normal tissue there is a balance between the generation of new cells via cell division and the loss of cells through cell death. Old cells become damaged over time and then go through a process called apoptosis, a form of programmed cell death. Apoptosis is one form of cellular suicide. Apoptosis is a very orderly process in which the genome of the cell, all of its genetic information, is broken down, The cell is fragmented into smaller pieces and the debris is taken in and digested by nearby cells (called phagocytic cells) .5 This process is normal and necessary for us to refresh our bodies with new, healthy cells.
When cells are reproducing (dividing), they go through a series of predictable events. Together, these events are called the cell cycle. Like one could find in a factory, there are checkpoints built into the cell cycle that stop the process when damage is present or something has gone wrong. Checkpoints can trigger the death of cells that are dividing in an abnormal way and are responsible for preventing the development of cancer.
The balance between life and death for a cell depends on the amounts and activity of two different types of signals. There are some proteins whose function is to keep cells alive (pro-survival) and there is another set that work to trigger cell death (pro-death).
There are several ways that cancer cells can avoid death by apoptosis. One way is to make too many pro-survival proteins. These work as a shield and prevent the cells from dying when they should. Another way is to produce inactive or defective pro-death proteins. This can happen when the genes that produce these proteins become mutated or silenced.
Avoidance of cell death, coupled with continued cell division leads to the growth of a tumor. Most of the chemotherapy drugs discussed in the Cancer Treatments section work by causing cancer cells to die by apoptosis.
The process of apoptosis, including nuclear fragmentation and the formation of many small cell fragments (called blebs), is shown in the animation below.
The image below shows human cancer (lymphoma) cells treated with the chemotherapy agent camptothecin. The cells that are undergoing apoptosis appear yellow and show the characteristic membrane blebbing (bubble formation) seen in cells dying via apoptosis.
Image used with permission; Molecular Probes.
Hallmarks of Cancer: Getting a Blood Supply

As a tumor grows larger, it uses more oxygen and nutrients. Eventually it will need to increase the supply of nutrients and oxygen it receives. This is done by causing the growth of new blood vessels. The process is called angiogenesis. Low oxygen levels (hypoxia) trigger the tumor and its surrounding environment to release signals that cause the growth of blood vessels towards and into the tumor. These new vessels supply oxygen and nutrients that allow the tumor to continue growing.6
Angiogenesis is a highly organized process. Existing blood vessels are recruited and extended in an orderly fashion.
Importantly, the blood vessels that are created in response to signals from cancer cells (and tumors in general) are NOT normal. The timing and amounts are not right. The result is that tumor blood vessels are defective. They are twisted and leaky. The vessels are also weak and this can allow the cancer to spread (metastasize) more easily by providing a way to get to distant parts of the body.7, 8
Because the development of blood vessels is so important in tumor growth and is a target of some cancer treatments, we have a full angiogenesis page.
Hallmark of Cancer: Metastasis

The spread of cancer from its original location to other parts of the body is called metastasis. This is a critical event in cancer. About 90% of the death associated with cancer is due to disease that has spread. On this page, we present an introduction to the steps in metastasis of a cancer cell. Because of its importance, we have also created a section on how cancer spreads.
Into the Blood
Intravasation, or the process of gaining entry into the blood circulation, is the first step in metastasis. 9 To accomplish this, cancer cells must move away from the primary tumor, which is able to happen due to changes on the cell's surface. Normal cells are held in place by sticky proteins called adhesion molecules. This ensures that cells remain closely linked to each other and the rest of the tissue they live in. However, some tumor cells no longer make correct/functional adhesion molecules, allowing the cell to move away from the tumor and possibly enter the blood stream. For normal cells, the loss of adhesion molecules results in their death. However, metastatic cells have mutations that allow them to survive without being attached by adhesion molecules. 10, 6
As mentioned in the previous section, the blood vessels in tumors are often defective. The loose, leaky structure makes it easier for cancer cells to invade the blood supply.
In the Blood
Once tumor cells have successfully entered the blood stream, they face an entirely new challenge: surviving transit in the blood. Most cells, including tumor cells, are not designed to survive the stresses of the blood system. One of the primary ways in which tumor cells survive this transit is by using platelets to act as shields. Platelets are small blood cells that can surround the cancer cells and protect them from both the force of blood flow and attacks from immune cells. 9
Out of the Blood
Extravasation, or exit from the blood vessel, is the final leg of the tumor cell's journey through the circulatory system. In some cases, tumor cells, which are often larger than blood cells, get stuck in the capillary bed of a distant organ. A capillary bed is the network of small blood vessels that are too narrow for the tumor cells to get through. Here they can continue to grow until they burst through the vessel. In other cases, extravasion is more specific. Tumor cells are often drawn to certain organs based on their adhesion molecules' abilities to bind to certain organ tissues better than others. 6 Evidence for this is observed in breast cancer, which frequently travels to the lung. Breast cancer cells are capable of interacting with an adhesion molecule specifically present on cells of the lung. 11
Changes in Physical Properties of Cancer Cells

The changes in cell behavior that occur as cancer develops are, in part, dependent on changes in physical properties of the cells. Some of the changes have been identified and may be used to identify cancer cells.
Tumor cells display a characteristic set of features that distinguish them from normal cells. These traits allow the individual cells to form a tumor mass and eventually to metastasize to other parts of the body. We will briefly consider the changes that affect cell functions and then discuss some of the capabilities that must be acquired by the tumors as a whole to enable them to grow and spread.
A wide range of changes occur during the transformation of a normal cell to a cell capable of forming a cancerous growth. All cancer cells acquire the ability to grow and divide in the absence of signals that are normally 'turned on' and/or in the presence of signals that are normally 'turned off'. There are also detectable changes in the physical properties of the cells. These changes include the following:
Cytoskeletal changes: The distribution and activity of components in the cell infrastructure, namely microfilaments and microtubules, may change. These alterations change the ways in which the cell interacts with neighboring cells and alter the appearance of the cells. Changes in the cytoskeleton also affect cell adhesion and movement (motility).
Cell adhesion/motility: The reduction of cell:cell and cell:extracellular matrix adhesion allows large masses of cells to form. As described in the section on cell division, cancer cells are able to continue to grow even when surrounded by other cells. The alterations in cell adhesion also impact on the ability of the cells to move. Cancer cells must be able to move and migrate in order to spread, and cell adhesion plays a major role in regulating cell movement.
Nuclear changes: The shape and organization of the nuclei of cancer cells may be markedly different from that of the nuclei of normal cells of the same origin. This change in appearance may be useful in the diagnosis and staging of tumors.
Enzyme production: Cancer cells often secrete enzymes that enable them to invade neighboring tissues. These enzymes digest away the barriers to migration and spread of the tumor cells.
Genetic Instability and Cancer
As described above, the development of cancer is complex and requires that the cells behave in a very abnormal way. Many of the changes are caused by changes (mutations) in important genes. The mutations take time to occur, but they are helped along by another common feature of cancer cells - they suffer more mutations than normal cells.
There are several reasons why cancer cells accumulate mutations more rapidly than normal cells. First, they often live in environments that contain many mutation-causing chemicals. Second, the cancer cells often do not repair DNA damage as well as normal cells.
The poor repair leads to more mutations and a downward spiral of mutation and cell damage. This is often made much worse when genes and pathways involved in DNA repair are themselves damaged. While all cells sustain damage to their DNA, normal cells can fix the problems and cancer cells become more damaged over time.
Cancer almost always arises from a single defective cell, but as they mutate and divide, the cells start to become different from each other. All defective, but not in exactly the same ways.
Summary
Hallmarks of Cancer
- Cancer typically arises from genetic changes to a single cell.
- Numerous changes are necessary to create a cancer cell from a normal cell.
- Additional changes must occur to allow a tumor to form and spread.
- Cancer cells must acquire the following set of capabilities in order to proliferate:
- Unlimited number of cell divisions
- Growth without external signals
- Failure to respond to 'stop' signals
- Avoidance of cell death
- Acquire an adequate food supply via the promotion of blood vessel formation
- The ability to leave the original tumor location and form a new tumor, or metastasis
Characteristics of Cancer Cells
- Cytoskeletal changes allow a cell to alter its appearance and interactions. Helps in cell motility.
- Cancer cells have less cell:cell and cell:surroundings connections allowing the cell to become mobile.
- A cancer cell's nucleus may be markedly different from that of a normal cell's.
- Cancer cells often secrete enzymes that allow it to invade neighboring tissues.
- Cancerous tissue is disorganized and appears abnormal.
Know The Flow: Hallmarks Of Cancer
Know the Flow is an interactive game for you to test your knowledge. To play:
- Drag the appropriate choices from the column on the right and place them in order in the boxes on the left. Note that you will only use five of the six choices to complete the game.
- When done, click on 'Check' to see how many you got correct.
- For incorrect answers, click on 'Description' to review information about the processes.
- To try again, choose 'Reset' and start over..
Please visit us on a larger screen to play this game.
- 1ab Adami, Hans-Olov, Hunter, David, Trichopoulos, Dimitrios. "Textbook of Cancer Epidemiology."Oxford University Press, 2002.
- 2ab Hanahan D, Weinberg RA. "The hallmarks of cancer." Cell (2000) 100: 57-70 [PUBMED]
- 3 SCHERER, W., SYVERTON, J., & GEY, G. (1953). Studies on the propagation in vitro of poliomyelitis viruses. IV. Viral multiplication in a stable strain of human malignant epithelial cells (strain HeLa) derived from an epidermoid carcinoma of the cervix. The Journal of Experimental Medicine, 97(5), 695–710. (Original work published May 1953) [PUBMED]
- 4 Masters, J. (2002). HeLa cells 50 years on: the good, the bad and the ugly. Nature Reviews. Cancer, 2(4), 315–9. (Original work published April 2002) [PUBMED]
- 5 Hengartner MO. "The biochemistry of apoptosis." Nature. 2000 Oct 12;407(6805):770-6. [PUBMED]
- 6abc Steeg, P.S. 2006. Tumor metastasis: mechanistic insights and clinical challenges. Nat Med. 12:895-904. [PUBMED]
- 7 Paduch, R. (2016). The role of lymphangiogenesis and angiogenesis in tumor metastasis. Cellular Oncology (Dordrecht), 39(5), 397–410. (Original work published October 2016) [PUBMED]
- 8 Folkman, J. (2002). Role of angiogenesis in tumor growth and metastasis. Seminars in Oncology, 29(6 Suppl 16), 15–8. (Original work published December 2002) [PUBMED]
- 9ab Gupta, G.P., and J. Massague. 2006. Cancer metastasis: building a framework. Cell. 127:679-95. [PUBMED]
- 10 Bacac, M., and I. Stamenkovic. 2008. Metastatic cancer cell. Annu Rev Pathol. 3:221-47. [PUBMED]
- 11 Brown, D.M., and E. Ruoslahti. 2004. Metadherin, a cell surface protein in breast tumors that mediates lung metastasis. Cancer Cell. 5:365-74. [PUBMED]